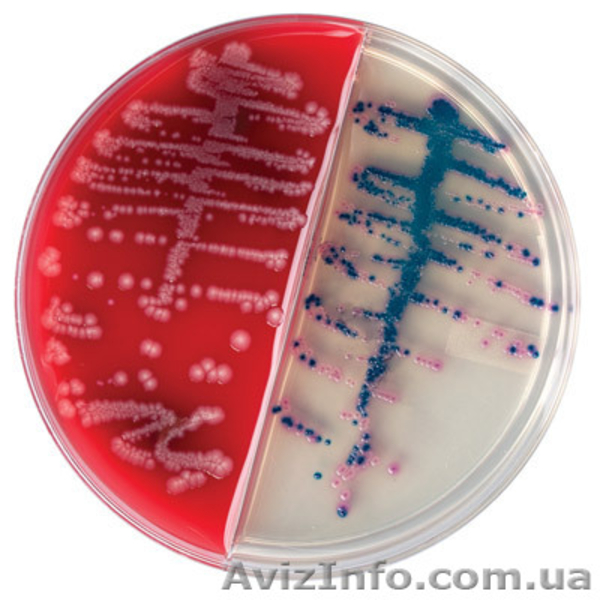
Среды для микробиологии - <ro>Изображение</ro><ru>Изображение</ru> #2, <ru>Объявление</ru> #1076505
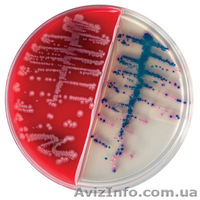
Среды для микробиологии - <ro>Изображение</ro><ru>Изображение</ru> #2, <ru>Объявление</ru> #1076505

Медичні послуги в Києві
BD Diagnostic Systems
Крупнейший производитель продукции для бактериологических исследований. Ассортимент систем для забора и транспортировки проб, питательные среды и тест-системы для выделения и идентификации микроорганизмов, а также широкий спектр аксессуаров, необходимых для исследований в санитарной и медицинской микробиологии. Одно из последних достижений - уникальные по своей простоте и чувствительности экспрессные тест-системы для идентификации широкого спектра грамположительных, грамотрицательных микроорганизмов, грибов, анаэробов. А также высококлассное оборудование, использующее новейшие технологии с возможностью организации единой лабораторной информационной базы данных (LIS).
BD Diagnostics Аналитические системы (EpiCenter)
BD Diagnostics Готовые питательные среды
BD Diagnostics Дегидратированные питательные среды
BD Diagnostics Автоматическая идентификация и определение чувствительности (Phoenix)
BD Diagnostics Красители и реагенты
BD Diagnostics Системы гемокультивирования (Bactec)
BD Diagnostics Системы для создания атмосферы
BD Diagnostics Тест системы
BD Diagnostics Транспортные системы
BD Diagnostics Полуавтоматическая система идентификации, бак. анализатор BD Crystal
BD Diagnostics Латексные тесты для быстрой идентификации патогенных микроорганизмов
BD Diagnostics Сухие питательные среды
BD Diagnostics Контрольные штаммы BD Microtrol
BD Diagnostics Диспенсеры дисков с антибиотиками BD Sensi-Disc
BD Diagnostics Диски с антибиотиками BD Sensi-Disc
BD Diagnostics Добавки к питательным средам, пептоны
Контакты для связи:
ООО «Диалог Диагностикс»
tel/fax: 38 044-390-37-76
mob. 38 096 702 86 41
email: Didkivskiy@dialogd.com
web: http://www.dialogd.com
Інформація про компанію, яка розмістила оголошення:
Дії з оголошенням #1076505
Поділіться з друзями і знайомими
Поділіться оголошенням Среды для микробиологии з друзями, знайомими, потенційними клієнтами, використовуйте для цього соціальні мережі, месенджери. Це додасть оголошенню популярності і ефект багаторазово підвищиться.
Збережіть або повідомте про порушення
Didkivskiy Didkivskiy
- На сайті з: 18.04.2014
- Активність: 18.04.2014
Поради з безпеки
- Познайомтеся з продавцем в публічному місці
- Перевірте товар перед покупкою
- Сплачуйте лише після того як переконаєтеся, що товар відповідає опису і вашим вимогам
- Бажано провести операцію при свідках
Інші оголошення від
Didkivskiy Didkivskiy
QR-код сторінки
Поділіться QR-кодом в соціальних мережах, чатах, месенджерах щоб ваші знайомі, потенційні клієнти відкрили ваше оголошення на своїх смартфонах.

Казахстан
Казахстан Україна
Україна Узбекистан
Узбекистан Молдова
Молдова